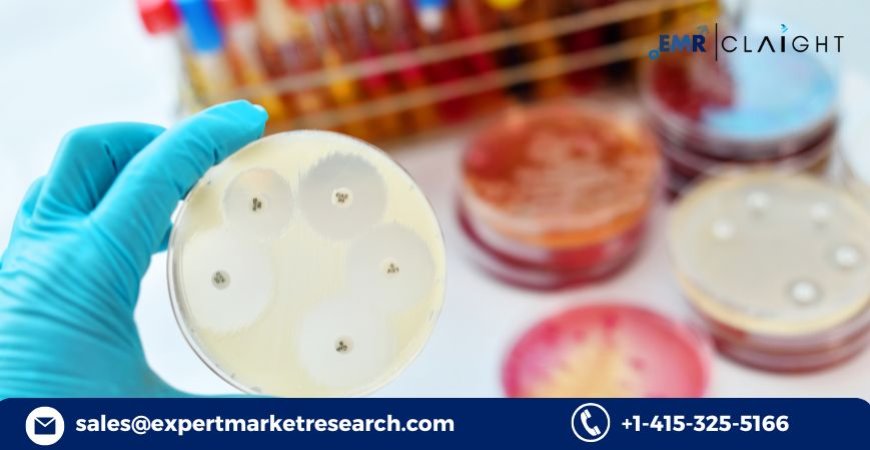

Patient Engagement Solutions Market: Demand Forecast and Future Growth (2034)
The patient engagement solutions market is transforming how healthcare providers and patients interact. These solutions include advanced tools and platforms that help patients actively participate in managing their health, improving outcomes and satisfaction.
Patient Engagement Solutions Market Overview
The patient engagement solutions market is transforming how healthcare providers and patients interact. These solutions include advanced tools and platforms that help patients actively participate in managing their health, improving outcomes and satisfaction. With growing digitization in healthcare and the demand for personalized care, patient engagement solutions are becoming an integral part of modern medical ecosystems. Hospitals, clinics, and other healthcare facilities increasingly rely on these systems to streamline communication, track patient progress, and deliver educational resources that empower patients to make informed decisions about their health.
Expert Market Research: Insightful Outlook for Patient Engagement Solutions
Expert Market Research highlights the transformative impact of digital health technologies on the patient engagement solutions market. By analyzing key trends and growth projections, their insights demonstrate how innovative platforms are redefining patient-provider interactions, encouraging active participation, and improving outcomes. As healthcare systems worldwide embrace these solutions, the markets impressive forecast signals a future where connected care and digital empowerment play a pivotal role in shaping a healthier, more informed global population.
Patient Engagement Solutions Market Size
In recent years, the global patient engagement solutions market has witnessed remarkable growth, reaching an estimated value of USD 22.74 billion in 2024. The increasing focus on improving patient experiences, coupled with advancements in digital health technologies, has significantly contributed to this expansion. As healthcare systems worldwide embrace innovative tools to enhance patient outcomes, the market is expected to gain substantial traction. With an impressive projected compound annual growth rate (CAGR) of 17.10% from 2025 to 2034, industry experts predict the market will surge to approximately USD 110.25 billion by 2034. This robust growth underscores the increasing adoption of digital health strategies and the commitment to value-based care models.
Patient Engagement Solutions Market Trends
Emerging trends are reshaping the patient engagement solutions market landscape. Telehealth integration has become a key trend, enabling real-time communication between patients and providers. Wearable devices and mobile health apps now allow continuous health monitoring, fostering proactive patient involvement. Additionally, artificial intelligence and data analytics are driving personalized care, helping healthcare professionals deliver insights tailored to individual needs. The rise in value-based reimbursement models motivates providers to prioritize patient engagement. Moreover, the shift toward remote patient monitoring and virtual consultations is expected to continue, fueled by the demand for accessible, convenient care options. These trends signal a future where patient empowerment and technology go hand in hand.
Patient Engagement Solutions Market Opportunities and Challenges
The patient engagement solutions market presents immense opportunities, including the adoption of AI-driven platforms, integration with electronic health records (EHRs), and the rise of telemedicine. These solutions enable efficient resource utilization, reduce hospital readmission rates, and improve overall patient outcomes. However, data privacy and security remain significant challenges, as patient information must be safeguarded against cyber threats. Limited digital literacy among certain patient populations and resistance to new technologies can also hinder widespread adoption. Overcoming these obstacles will require industry stakeholders to invest in user-friendly platforms, robust cybersecurity measures, and educational initiatives that help patients and providers fully harness the potential of engagement tools.
For more information about this report visit
Patient Engagement Solutions Market Segmentation
- By Component:
- Hardware
- Software
- Services
- By Delivery:
- Cloud-Based
- On-Premises
- By Functionality:
- Communication
- Health Tracking and Insights
- Billing and Payments
- Administrative
- Patient Education
- Others
- By Therapeutic Area:
- Health and Wellness
- Chronic Disease Management
- Others
- By Application:
- Population Health Management
- Outpatient Health Management
- In-patient Health Management
- Others
- By End User:
- Payers
- Providers
- Others
- By Region:
- North America
- Europe
- Asia Pacific
- Latin America
- Middle East and Africa
Patient Engagement Solutions Market Growth
The growth trajectory of the patient engagement solutions market is driven by several key factors. Governments and healthcare organizations worldwide are implementing policies that encourage patient-centric approaches, prompting providers to adopt digital engagement tools. The increasing prevalence of chronic diseases requires ongoing patient monitoring and support, which these solutions effectively address. Furthermore, technological advancements such as cloud computing and big data analytics make it easier for providers to gather, analyze, and share patient information securely. As healthcare systems transition from volume-based to value-based care, the emphasis on positive patient experiences and outcomes fuels market expansion. This strong growth outlook positions patient engagement solutions as a vital component of tomorrows healthcare landscape.
Patient Engagement Solutions Market Forecast
The patient engagement solutions market is set for substantial expansion in the coming years. With the market size projected to soar from USD 22.74 billion in 2024 to approximately USD 110.25 billion by 2034, healthcare providers and technology companies are expected to invest heavily in digital transformation strategies. The forecasted CAGR of 17.10% highlights strong market confidence and the growing recognition of these solutions as essential to modern healthcare delivery. As telemedicine, remote patient monitoring, and mobile health apps continue to gain popularity, the demand for integrated engagement platforms will rise. This positive forecast underscores the industrys focus on empowering patients and delivering high-quality, connected care globally.
Patient Engagement Solutions Market Competitor Analysis
The competitive landscape of the patient engagement solutions market features major players who constantly innovate to maintain market leadership. Companies are focusing on partnerships, product launches, and technological advancements to enhance their offerings and expand their global reach.
- Nextgen Healthcare, Inc.: Provides intuitive solutions that improve patient-provider communication.
- Epic Systems Corporation: Develops comprehensive health records and patient engagement tools.
- McKesson Corporation: Delivers advanced platforms for connected care.
- Koninklijke Philips N.V.: Focuses on integrated solutions for remote patient monitoring.
- Klara Technologies, Inc.: Offers secure messaging and patient communication tools.
- Computer Programs and Systems, Inc: Provides community-based healthcare IT solutions.
- IBM Corporation: Integrates AI and analytics for enhanced patient insights.
- Others: Continue to shape the competitive landscape through innovation.
Find More Report:































